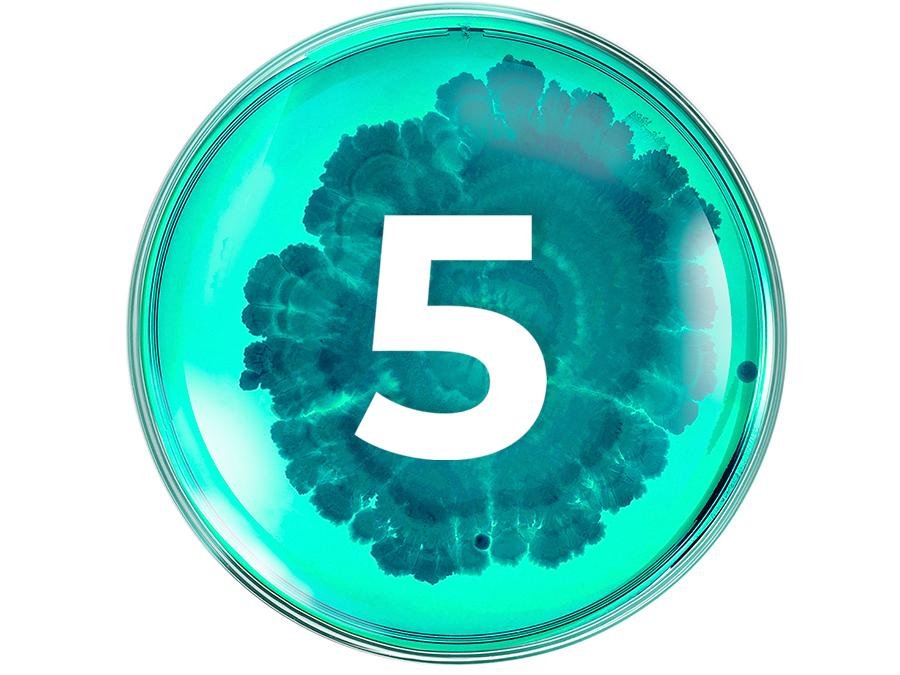
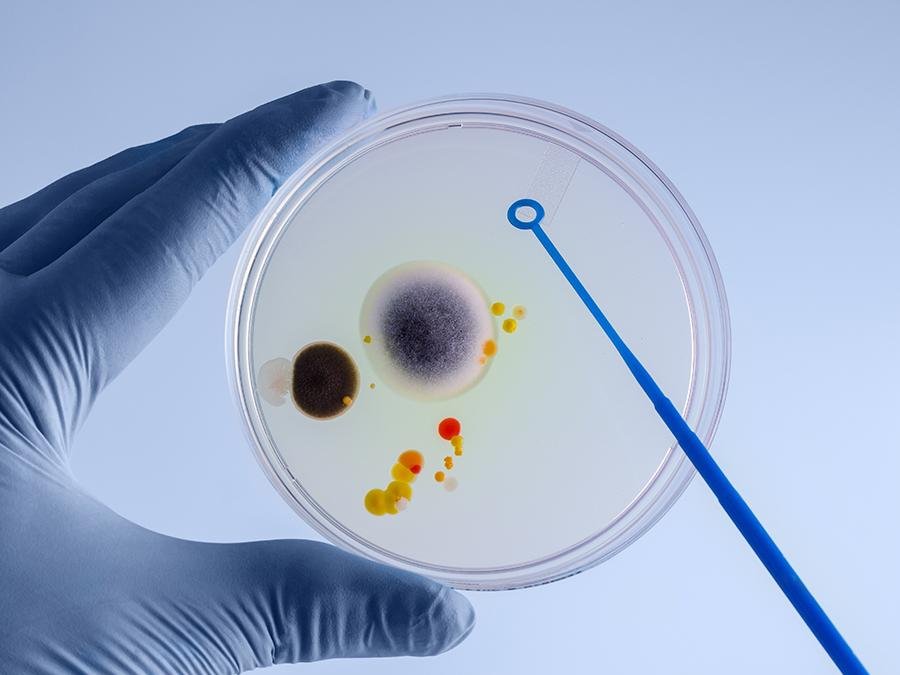

What will probiotics do for my skin?
Probiotics are immensely beneficial. They out-compete pathogenic microbes, improve barrier function, produce moisturising factors, maintain skin pH and reduce sensitivity and inflammation. All these factors reduce the rate of skin…